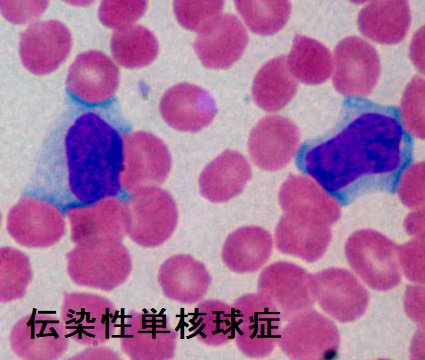
伝染性単核球症 異型リンパ球 伝染性単核球症 異型リンパ球

ヘルペスウイルスと甲状腺;伝染性単核球症、EBウイルス、突発性発疹[日本甲状腺学会認定 甲状腺専門医 橋本病 バセドウ病 長崎甲状腺クリニック 大阪]
甲状腺専門の検査/治療/知見③ 橋本病 バセドウ病 甲状腺エコー 長崎甲状腺クリニック大阪
甲状腺専門の長崎甲状腺クリニック(大阪府大阪市東住吉区)院長が海外・国内論文に眼を通して得た知見、院長自身が大阪市立大学 大学院医学研究科 代謝内分泌病態内科学で得た知識・経験・行った研究、毎年どこかで開催される日本甲状腺学会で入手した知見です。
長崎甲状腺クリニック(大阪)以外の写真・図表はPubMed等において学術目的で使用可能なもの(Creative Commons License)、public health目的で官公庁・非営利団体等が公表したものを一部改変しています。引用元に感謝いたします。尚、本ページは長崎甲状腺クリニック(大阪)の経費で非営利的に運営されており、広告収入は一切得ておりません。
甲状腺・動脈硬化・内分泌代謝・糖尿病に御用の方は 甲状腺編 動脈硬化編 内分泌代謝(副甲状腺/副腎/下垂体/妊娠・不妊等 糖尿病編 をクリックください
長崎甲状腺クリニック(大阪)は甲状腺専門クリニックです。ヘルペスウイルスの病気、伝染性単核球症の治療を行っておりません。
Summary
ヘルペスウイルスと甲状腺。亜急性甲状腺炎と鑑別を要する伝染性単核球症はEBウイルス(エプスタイン・バールウイルス:EBV)、サイトメガロウイルス(CMV)が原因で、甲状腺機能亢進症/バセドウ病・無痛性甲状腺炎を発症する事も。甲状腺癌患者はEBVの陽性率が高い。EBVはメトトレキサート(MTX)誘発甲状腺悪性リンパ腫、バーキットリンパ腫、ホジキンリンパ腫、亜急性甲状腺炎を発症。突発性発疹は乳児期のヒトヘルペスウイルス6型(HHV‐6)かHHV-7感染が原因で、橋本病に関係している説がある。
keywords
亜急性甲状腺炎,ヘルペス,EBウイルス,甲状腺機能亢進症,伝染性単核球症,バセドウ病,突発性発疹,橋本病,甲状腺,甲状腺癌
伝染性単核球症とは
亜急性甲状腺炎と鑑別を要する伝染性単核球症。喉(のど)の痛みと首のリンパ節の腫れを甲状腺の病気と思って、長崎甲状腺クリニック(大阪)を受診される方がおられます。
伝染性単核症(infectious mononucleosis, IM)は思春期頃にヘルペスウイルスの一種、
- EBウイルス(エプスタイン・バールウイルス:Epstein-Barr virus:EBV)
- 頻度は少ないがサイトメガロウイルス(CMV) やHIV
に初感染して発症します。唾液感染するためキス病(kissing disease)とも呼ばれます。
80%以上の人は乳幼児期にEBウイルスの初感染を受け、軽い感冒様症状で終わるので伝染性単核症を発症しません。
伝染性単核球症の症状
伝染性単核球症の症状は、
- 38 ℃以上の高熱が1〜2週間持続
- 眼瞼浮腫;他のウイルス・細菌感染でも起きる[甲状腺眼症(バセドウ病眼症)のよう]
- 扁桃は白苔・偽膜形成を伴い、咽頭痛(溶連菌などによる細菌性扁桃腺炎と鑑別)
- 痛みを伴う著明な後頸部リンパ節腫脹は1〜2週頃がピークで、耳下腺の下、外側頚部まで累々と広がり、全身のリンパ節も腫大します。
亜急性甲状腺炎や溶連菌感染症では前頸部リンパ節腫大
- 1〜2週間後、体幹、上肢を中心に麻疹様紅斑、ヘルペス感染症に特徴的な癒合傾向
- 肝脾腫;わずかな衝撃でも脾臓破裂を来す事がある[ほとんどが3週間以内に起きるため、最低3週間(できれば最初の1カ月)は運動制限が必要。激しい運動、コンタクトスポーツは制限期間を更に延長した方が無難。(Clin J Sport Med. 2008 Jul;18(4):309-15.)]
伝染性単核球症の検査所見・治療
伝染性単核球症で甲状腺機能亢進症/バセドウ病・無痛性甲状腺炎を発症
伝染性単核球症に罹患後、2-4週間で甲状腺機能亢進症/バセドウ病を発症する事があります[Intern Med. 2010;49(23):2599-603.]。甲状腺機能亢進症/バセドウ病を発症しなくても、伝染性単核球症の急性期にバセドウ病抗体TRAb力価が一過性に上昇した報告もあります[Springerplus. 2015 Aug 27;4:456.]。
その理由として、
- 伝染性単核球症になる前、既に軽度の甲状腺機能亢進症/バセドウ病(潜在性甲状腺機能亢進症など)だった人が増悪した
- もともとバセドウ病素因のある人が、伝染性単核球症に伴う炎症性サイトカイン上昇(サイトカインストーム)により自己免疫反応を誘導された
- EBウイルス(エプスタイン・バールウイルス)自体が、甲状腺機能亢進症/バセドウ病を誘発
と考えられます。
伝染性単核球症以外では、
による甲状腺機能亢進症/バセドウ病の誘発が有名です。(日本甲状腺学会雑誌 2(1), 45-47, 2011-04)
また、伝染性単核球症をおこさなくてもEBウイルス(エプスタイン・バールウイルス)自体が、甲状腺機能亢進症/バセドウ病を発症させる原因の一つとされます(エプスタイン‐バールウイルス (EBV) でバセドウ病発症)。
一方、伝染性単核球症後に無痛性甲状腺炎を発症する事もあります。(第60回 日本甲状腺学会 P2-4-2 伝染性単核球症発症後に発症したバセドウ病と無痛性甲状腺炎の 鑑別に苦慮した一例)
EBウイルス(エプスタイン・バールウイルス)は、上咽頭に感染し、
の原因になります。
また、Bリンパ球に感染し、
- 伝染性単核球症
- 悪性リンパ腫(ホジキンリンパ腫 バーキットリンパ腫 メトトレキサート(MTX)誘発のMTX 誘発甲状腺悪性リンパ腫 )
- バセドウ病発症(下記)
- 亜急性甲状腺炎(Int J Pediatr Otorhinolaryngol. 2003 May;67(5):447-51.)[An Med Interna. 2000 Oct;17(10):546-8.]
3歳女児で発症した報告[Thyroid. 2005 Oct;15(10):1189-91.]
ヘルペスウイルスの一種、エプスタイン‐バールウイルス (EBV) が持続感染しているBリンパ球の細胞表面には、バセドウ病の原因となる甲状腺刺激ホルモン受容体抗体(TRAb) が現れます。エプスタイン‐バールウイルス (EBV) が再活性化されると、宿主B細胞が形質細胞へ分化し、TRAb産生を開始します。
これが、一つのバセドウ病発症メカニズムとされます。(Viral Immunol. 2017 Apr;30(3):240-249.)
もちろん、全ての甲状腺機能亢進症/バセドウ病が、エプスタイン‐バールウイルス (EBV) によって発症する訳では無いと思います。バセドウ病に関与するHLA抗原(HLA-A2、HLA-DPB1*05:01)も一部見つかっており(ついに甲状腺にもHLA遺伝子診断)、バセドウ病家系は普通に存在します。
その他、急性扁桃炎(溶連菌感染)やエルシニア感染症もバセドウ病発症に関与するとされ、原因は複数存在します。
急性エプスタイン‐バールウイルス (EBV) 感染症で、白血球減少症および高度の好中球減少症を来すケースがあります[Sangre (Barc). 1997 Jun;42(3):258-9.]。
抗甲状腺薬メルカゾール内服で安定している甲状腺機能亢進症/バセドウ病患者が急性エプスタイン‐バールウイルス (EBV) 感染症をおこし、好中球数が350/μLまで低下した報告があります。メルカゾール中止により甲状腺機能亢進症/バセドウ病が再発した後、メルカゾール再開すると、回復していた好中球数が再度860/μLまで減少したそうです。(第67回 日本甲状腺学会 HS3-2 P18-2 EBウィルス感染再燃を契機に好中球減少症を発症したバセドウ病の一例)。
抗甲状腺薬(メルカゾール)服薬中の新型コロナウイルス感染(COVID-19)で無顆粒球症をきたした報告はありますが、筆者が調べた限りエプスタイン‐バールウイルス (EBV) 感染での報告は無く、貴重な症例を教えていただきました。
発癌性を持つヒトパピローマウイルス18(HPV-18)は頭頸部癌の危険因子とされます(Medicine (Baltimore). 2019 Feb;98(8):e14551.)。
健常人と比べると、乳癌患者はヒトパピローマウイルス(HPV) とエプスタイン‐バールウイルス (EBV) の陽性率が高く、甲状腺癌患者はEBVの陽性率が有意に高い。HPVタンパクとEBVタンパクは乳癌細胞に、EBVタンパクは、それより弱いながらも甲状腺癌細胞に直接的および関節的な影響を及ぼすとされます。(Asian Pac J Cancer Prev. 2020 May 1;21(5):1431-1439.)
また、甲状腺未分化癌の方が、甲状腺乳頭癌よりもEBV核抗原-2(EBNA2)の発現割合が高く、甲状腺乳頭癌の未分化転化に関与している可能性があります。[Hum Pathol. 2003 Nov;34(11):1170-7.]
その他、エプスタイン‐バールウイルス (EBV) が甲状腺に関与する病態として、
- メトトレキサート(MTX)誘発のMTX 誘発甲状腺悪性リンパ腫
- バーキットリンパ腫
- ホジキンリンパ腫
- 亜急性甲状腺炎 (Int J Pediatr Otorhinolaryngol. 2003 May;67(5):447-51.)
- 亜急性甲状腺炎と鑑別を要する伝染性単核球症を発症
などがあります。
ヒトヘルペスウイルス6型(HHV‐6)は橋本病(慢性甲状腺炎)患者において活性化しており、その発症に関係している可能性があります(真偽は現時点で不明)。[PLoS Pathog 2012; 8: e1002951.]
また、ヒトヘルペスウイルス6型(HHV‐6)は、薬剤誘発性過敏症(薬剤過敏症症候群) において再活性化されます。
小児での熱性けいれん重積では、速やかなけいれん頓挫が必要。持続する全身けいれん・チアノーゼを認めれば、る直ちに、
- 酸素投与
- 気道確保
- 静脈路確保
- 抗けいれん薬(ジアゼパムかミダゾラム)静脈投与;呼吸抑制に注意
熱性けいれんと思っても、急性脳炎・髄膜炎、甲状腺クリーゼの場合もあるため、けいれん頓挫後に鑑別診断が必要。
- 熱性けいれん症状で発症した生後2歳9カ月児の甲状腺クリーゼ[Pediatrics. 2020 Feb;145(2):e20191920.]
- 熱性てんかん重積症を呈した3歳女児の甲状腺クリーゼ[Front Pediatr. 2023 Jun 16:11:1213040.]
の報告があります。
甲状腺関連の上記以外の検査・治療 長崎甲状腺クリニック(大阪)
長崎甲状腺クリニック(大阪)とは
長崎甲状腺クリニック(大阪)は日本甲状腺学会認定 甲状腺専門医[橋本病,バセドウ病,甲状腺超音波(エコー)検査など]による甲状腺専門クリニック。大阪府大阪市東住吉区にあります。平野区,住吉区,阿倍野区,住之江区,松原市,堺市,羽曳野市,八尾市,天王寺区,東大阪市,生野区,浪速区も近く。